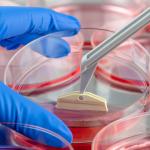
Разработват нов метод за регенериране на различни видове тъкани

Учени регенерираха успешно оптични нервни клетки на мишка в лабораторни условия
Учени откриха нов начин, посредством който да регенерират увредени оптични нервни клетки, взети от мишка и отгледани в лабораторни условия. За в бъдеще това вълнуващо постижение би могло да доведе до потенциалното лечение на различни очни заболявания.
Щетите, нанесени върху напълно развитите нервни клетки, може да предизвика необратими и животопроменящи последствия, тъй като веднъж щом нервните фибри достигнат зрялост, те губят способността си да се регенерират и не могат да се възстановят след нараняване или заболяване. Новите експерименти показват как активирането на част от регенеративния механизъм на нервните клетки – протеин, известен като протрудин – би могъл да стимулира нервите в окото да се възстановят след нараняване.
Постижението представлява стъпка напред в откриването на лечения за глаукома – група от очни заболявания, които довеждат до загуба на зрението вследствие на щети, нанесени върху оптичния нерв (който свързва очите с мозъка).
„Това е най-силната регенеративна техника, която сме използвали до момента – казва офталмологът Кийт Мартин от Мелбърнския университет в Австралия. – В миналото регенерирането на оптичния нерви изглеждаше невъзможно, но това проучване показва потенциала на генната терапия да стори именно това.“
Учени са постигали успехи във възстановяването на зрението на мишки и преди. През 2016-а изследователи успяват да възстановят зрението на мишки след инжектирането на светлочувствителни клетки, впоследствие се развиват в градивни елементи на ретината. Две седмици след по-късно мишките имат формирана ретина, посочва изследването, публикувано в сп. Proceedings of the National Academy of Sciences.
"Създадохме наново цялата структура - по същество това е първото доказателство, че може да вземете напълно сляпа мишка, да вкарате клетките и да реконструирате целия светлочувствителен слой", казва проф. Робърт Макларън от Оксфорд.
Предишни изследвания показват сходни резултати, но при мишки с частично повредена ретина. Според Макларън "това е като да възстановите целия компютърен екран вместо само да поправите отделни пиксели."
През 2012-а пък учени възстановяват „основното“ зрение на възрастна мишка, след като регенерират нервите по цялото протежение на оптичния път.
Изследването е публикувано в Scientific Reports.